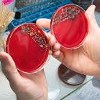

Другие названия и синонимы
Sowing of scraped/separated skin on microflora.
Описание
Посев стружки / отделяемой кожи в микробиоту с определением чувствительности к антибиотикам включает посев (бактериологический) посев и выявление возбудителей кожных заболеваний, изучение их восприимчивости к химиотерапевтическим препаратам. Материалом для бакпосев могут служить кожные чешуи, содержимое элементов сыпи (везикулы, пустулы, отделяемые язвы, эрозии). В ходе бакпосева выделяются чистые культуры (штаммы) микроорганизмов, проводится их идентификация и количественное определение в единицах колонообразования (КОЕ). Бакпосев позволяет выбрать антибиотик, антисептик или бактериофаг, эффективный против возбудителя.
|
|
Номенклатурные коды
- A26.07.005 Микробиологическое (культуральное) исследование абсцессов на аэробные и факультативно-анаэробные микроорганизмы
- A26.07.003 Микробиологическое (культуральное) исследование абсцессов на неспорообразующие анаэробные микроорганизмы
- A26.01.013 Микробиологическое (культуральное) исследование биоптата кожи на дрожжевые грибы
- A26.01.022 Микробиологическое (культуральное) исследование волос на грибы дерматофиты (Dermatophytes)
- A26.01.004 Микробиологическое (культуральное) исследование гнойного отделяемого диабетических язв на анаэробные микроорганизмы
- A26.01.001.001 Микробиологическое (культуральное) исследование гнойного отделяемого из пупочной ранки на аэробные и факультативно-анаэробные микроорганизмы
- A26.01.032 Микробиологическое (культуральное) исследование отделяемого высыпных элементов кожи на чувствительность к антибактериальным и противогрибковым препаратам
- A26.25.001 Микробиологическое (культуральное) исследование отделяемого из ушей на аэробные и факультативно-анаэробные микроорганизмы
- A26.25.004 Микробиологическое (культуральное) исследование отделяемого из ушей на дрожжевые грибы
- A26.25.005 Микробиологическое (культуральное) исследование отделяемого из ушей на мицелиальные грибы
- A26.26.006 Микробиологическое (культуральное) исследование отделяемого с век (соскобы с язв) на аэробные и факультативно-анаэробные условно-патогенные микроорганизмы
- A26.01.003 Микробиологическое (культуральное) исследование пунктата из ожога на аэробные и факультативно-анаэробные микроорганизмы
- A26.01.002 Микробиологическое (культуральное) исследование пунктата из пролежня на аэробные и факультативно-анаэробные микроорганизмы
- A26.01.014 Микробиологическое (культуральное) исследование пунктата пролежня кожи на дрожжевые грибы
- A26.01.038.002 Микробиологическое (культуральное) исследование пунктата пролежня кожи на жидких питательных средах на микобактерий туберкулеза (Mycobacterium tuberculosis complex)
- A26.01.038 Микробиологическое (культуральное) исследование пунктата пролежня кожи на микобактерий туберкулеза (Mycobacterium tuberculosis complex)
- A26.01.038.001 Микробиологическое (культуральное) исследование пунктата пролежня кожи на плотных питательных средах на микобактерий туберкулеза (Mycobacterium tuberculosis complex)
- A26.02.001 Микробиологическое (культуральное) исследование раневого отделяемого на аэробные и факультативно-анаэробные микроорганизмы
- A26.02.002 Микробиологическое (культуральное) исследование раневого отделяемого на возбудителей газовой гангрены (Clostridium spp.)
- A26.02.004 Микробиологическое (культуральное) исследование раневого отделяемого на грибы (дрожжевые, мицелиальные)
- A26.02.003 Микробиологическое (культуральное) исследование раневого отделяемого на неспорообразующие анаэробные микроорганизмы
- A26.01.010 Микробиологическое (культуральное) исследование соскоба с кожи на грибы (дрожжевые, плесневые, дерматомицеты)
- A26.01.023 Микробиологическое (культуральное) исследование соскобов с кожи и ногтевых пластинок на грибы дерматофиты (Dermatophytes)